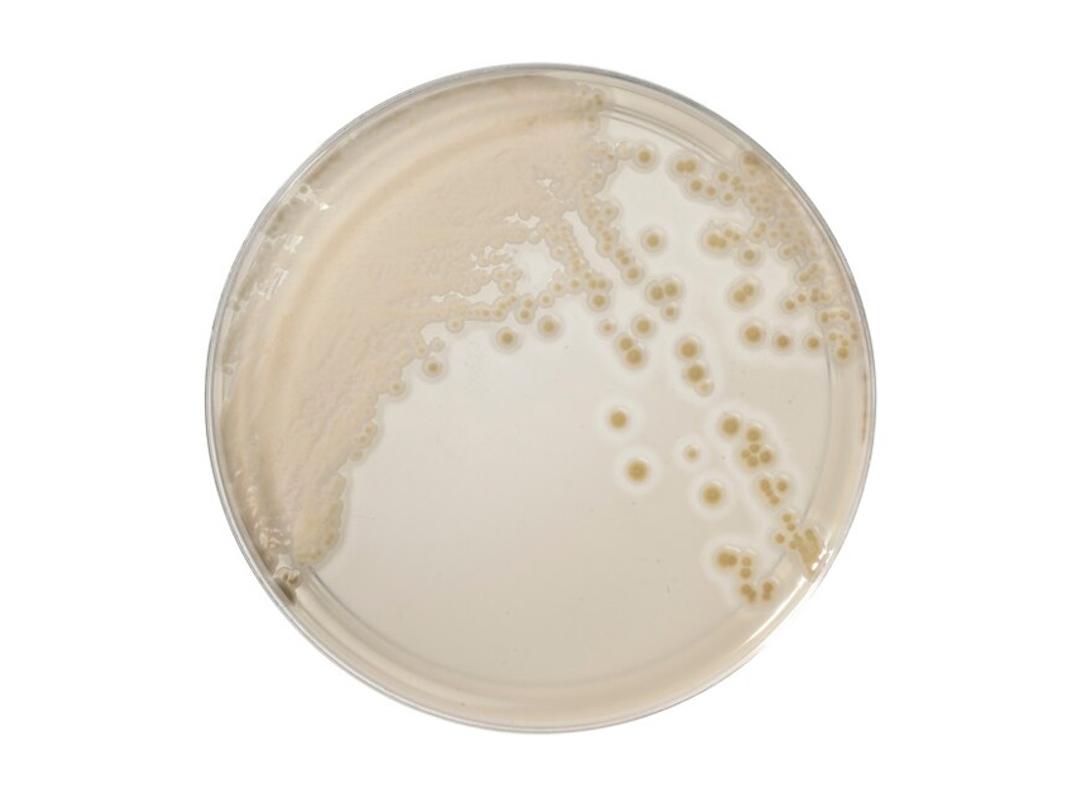
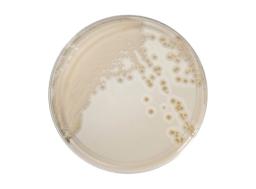

Thermo Scientific™ Brilliance™ Candida 2 Agar
Discover this innovative Candida detection and differentiation agar, designed to improve the detection and differentiation of Candida species, including screening and direct identification of C. auris and differentiation of five other clinically relevant species.
Thermo Scientific™’s improved chromogenic Candida Agar provides an upgrade from from traditional media and our existing chromogenic media. This medium enables fast, accurate detection, presumptive identification, and screening of both pathogenic and non-pathogenic Candida species-including critical pathogens like Candida auris. It offers colorful, easy-to-interpret colony differentiation and reduced incubation time when compared to traditional and existing chromogenic media. Unlike conventional media, our chromogenic solution offers the added benefits of room temperature storage up to 5 days and screening of C. auris , setting a new standard for speed and clarity in fungal detection. The agar is designed to be used in a diagnostic workflow to aid clinicians in determining potential treatment options for patients suspected of having Candida infections.
Key Features:
- Direct Identification of C. auris: This novel agar enables clear and precise identification of C. auris, a significant advancement in Candida diagnostics.
- Differentiation of Six Clinically Relevant Species: The medium differentiates C. albicans , C. glabrata , C. tropicalis , C. krusei , and C. parapsilosis/C. lusitaniae , providing comprehensive insights into Candida infections.
- Enhanced Performance: Assessed against a commercially available alternative (Comparator Medium) for limit of detection (LOD), analytical sensitivity (inclusivity), analytical specificity (exclusivity), and performance with diverse clinical specimens.
Benefits:
- High Analytical Sensitivity: Detects even low concentrations of Candida species, ensuring reliable results to support clinical diagnostics.
- Specificity and Inclusivity: Demonstrates high analytical specificity and inclusivity, distinguishing between different Candida species with high sensitivity and specificity results precision.
- Clinical Specimen Performance: Proven performance with a wide range of clinical specimens, making it a versatile tool for laboratories.